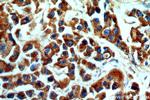
KMO Antibody in Immunohistochemistry (Paraffin) (IHC (P))

Search
Proteintech
KMO Polyclonal Antibody
{{$productOrderCtrl.translations['antibody.pdp.commerceCard.promotion.promotions']}}
{{$productOrderCtrl.translations['antibody.pdp.commerceCard.promotion.viewpromo']}}
{{$productOrderCtrl.translations['antibody.pdp.commerceCard.promotion.promocode']}}: {{promo.promoCode}} {{promo.promoTitle}} {{promo.promoDescription}}. {{$productOrderCtrl.translations['antibody.pdp.commerceCard.promotion.learnmore']}}
产品信息
10698-1-AP
种属反应
已发表种属
宿主/亚型
分类
类型
抗原
偶联物
形式
浓度
规格
纯化类型
保存液
内含物
保存条件
运输条件
产品详细信息
Immunogen sequence: LSVSRENLN KDLLTAAEKY PNVKMHFNHR LLKCNPEEGM ITVLGSDKVP KDVTCDLIVG CDGAYSTVRS HLMKKPRFDY SQQYIPHGYM ELTIPPKNGD YAMEPNYLHI WPRNTFMMIA LPNMNKSFTC TLFMPFEEFE KLLTSNDVVD FFQKYFPDAI PLIGEKLLVQ DFFLLPAQPM ISVKCSSFHF KSHCVLLGDA AHAIVPFFGQ GMNAGFEDCL VFDELMDKFS NDLSLCLPVF SRLRIPDDHA ISDLSMYNYI EKNMERFLHA IMPSTFIPLY TMVTFSRIRY HEAVQRWHWQ KR (107-407 aa encoded by BC005297)
靶标信息
Kynurenine 3-monooxygenase (KMO; EC 1.14.13.9) is an NADPH-dependent flavin monooxygenase that catalyzes the hydroxylation of the L-tryptophan metabolite L-kynurenine to form L-3-hydroxykynurenine.
仅用于科研。不用于诊断过程。未经明确授权不得转售。
生物信息学
蛋白别名: hK3OH-2; kmo; kmo {ECO:0000312|RGD:620610}; Kynurenine 3-hydroxylase; kynurenine 3-hydroxylase {ECO:0000255|HAMAP-Rule:MF_03018}; Kynurenine 3-monooxygenase; kynurenine 3-monooxygenase {ECO:0000255|HAMAP-Rule:MF_03018}; unnamed protein product
基因别名: AI046660; dJ317G22.1; KMO
UniProt ID: (Human) O15229, (Mouse) Q91WN4, (Rat) O88867
Entrez Gene ID: (Human) 8564, (Mouse) 98256, (Rat) 59113